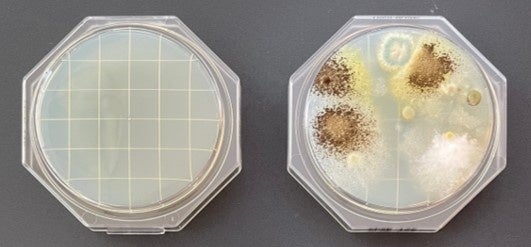

ドライとウエットが裏表で1枚になった画期的なワイパーシートで”新しい拭き掃除”を提案 「キレキラ!ワイパー ドライ×ウエットシート」新発売
いつでもパパっと、キレイをササっと 「ちょこっと掃除」に片面ずつがちょうどいい!
衛生用紙製品No.1ブランド※1の「エリエール」を展開する大王製紙株式会社(本社:東京都千代田区)は、住空間の“キレイを気楽に”する拭き掃除ブランド「キレキラ!」から、独自開発の3層構造シートを採用し、ドライ面とウエット面の表裏一体化を実現したワイパーシート「キレキラ!ワイパー ドライ×ウエットシート」(読み方:ドライバイウエットシート)(2商品)を2025年10月1日(水)から全国発売します。




■発売の狙い
近年、共働き世帯が全国で1,200万世帯を超える※2中、ライフスタイルが変わり、掃除にかけるひと手間を減らしたいという需要が高まっています。当社が実施した調査※3によると、床掃除をする際に「複数の掃除道具を使わず、もっと楽に掃除したい」(71.2%)、「1回の床掃除にかける時間を短くしたい」(68.7%)といった“簡単・時短”へのニーズが多くあげられました。また、忙しい日々での掃除への心理的負担から「忙しくて時間がない時でも、ササっと床掃除がしたい」(69.8%)、「汚れを溜めないように、ちょこちょこ気軽に掃除をしたい」(67.1%)といったスキマ時間に行う“ちょこっと掃除”への需要も多く、掃除はまとめて大規模に行うよりも、日々ちょこっとずつ、手軽に行いたいというニーズがうかがえます。
また、床汚れの種類には、髪の毛・ホコリ・花粉といった繊維で絡め取るものと、こびりついた汚れや皮脂汚れ、菌・ウイルスといったウエットシートで除去するものと2種類あり、汚れ別にシートも2種類ありますが、「ドライとウエットのシートの付け替えが手間」「ウエットシートは狭い範囲の掃除に使いにくく両面を使いきれないのでもったいない」といった声があがりました。
そこでこのたび、このようなニーズに応える新しい拭き掃除アイテムとして、ドライ面とウエット面が表裏で一体化したワイパーシート「キレキラ!ワイパー ドライ×ウエットシート」を新発売します。ドライ面でホコリや髪の毛をキャッチし、ウエット面でべたべた汚れを落とすことができるため、いつでもパパっと、床をササっとキレイにすることができます。あわせて、『キレキラ!ワイパー 本体』も、パッケージをリニューアルして発売。ヘッド裏が汚れても外して洗えるため、清潔に使用できます。「キレキラ!」がお届けする新しい拭き掃除スタイルを、ぜひご体感ください。
■商品について
「キレキラ!ワイパー ドライ×ウエットシート」は、当社紙おむつの防水シートを使用して独自開発した「キレキラ!ドライ×ウエット3層構造シート」を採用。機能が異なるドライ面とウエット面の表裏一体化を実現しました。ホコリや髪の毛を繊維で絡め取るドライ面と、飲みこぼしや皮脂などのべたべた汚れを洗浄成分でスッキリ落とすウエット面が一体なので、裏返すだけでシート交換でき、シートを取りに行く・付け替えるといった手間を削減し、無駄なく”ちょこっと掃除”ができます。また、本商品だけで床掃除を済ませることができるため、収納スペースやごみ削減にも繋がります。ウエット面には、除菌99.9%※4、ウイルス除去※4※5、24時間抗菌※4効果を備え、床を清潔に保ちます。
※1:インテージSRI+ ティシュー市場、トイレットペーパー市場、キッチンペーパー市場、ペーパータオル市場の合算(2024年度メーカー別売上金額)
※2:総務省統計局「労働力調査(詳細集計)(年平均)」
※3:当社調べ 2025年1月WEB調査(n=全国20~69歳男女1,380人、月1回以上床掃除従事者)
※4:特定の菌(及びウイルス)・条件下でウエット面での効果を検証すべての菌・ウイルスに同様の効果が得られるものではありません。
※5:エンベロープタイプのウイルス1種でウエット面での効果を検証。液が多い状態でご使用ください。
― 「キレキラ!ワイパー ドライ×ウエットシート」商品概要 ―
【商 品 名】キレキラ!ワイパー ドライ×ウエットシート
【発 売 日】2025年10月1日(水)から全国発売
【商品内容】2商品/オープン価格
◎キレキラ!ワイパー ドライ×ウエットシート 16枚
◎キレキラ!ワイパー ドライ×ウエットシート 32枚(16枚×2パック)
【商品規格】各社共通タイプ(シートサイズ:約300mm×200mm)
【公式HP】https://www.elleair.jp/kirekira/wiper/
【お問い合わせ】
エリエールお客様相談室 フリーダイヤル:0120-205205(土日祝日を除く)
お問い合わせフォーム:https://www.elleair.jp/inquiry/rules
― 商品特長 ―
■独自開発の「キレキラ!ドライ×ウエット3層構造シート」で、ドライ面とウエット面が表裏で一体化!いつでもパパっと、キレイをササっと「ちょこっと掃除」に片面ずつがちょうどいい!【NEW】
・ドライ面:ホコリ・髪の毛・花粉などを繊維で絡め取りしっかりキャッチ
・中層:当社紙おむつで使用している防水シート。水分を通さないため、表と裏で異なる機能を持つシートを実現
・ウエット面:洗浄成分を含んだ湿ったシートで、こびりつき・飲みこぼし・皮脂汚れなどをすっきり落とす

<「ちょこっと掃除」シーン>



■除菌99.9%、ウイルス除去、24時間抗菌効果で、床も心もすっきり!【NEW】
・ウエット面に、除菌99.9%、ウイルス除去、24時間抗菌効果を備え、清潔な床を保ちます。
■『キレキラ!ワイパー本体』のパッケージをリニューアル!【NEW】
・今回の発売にあわせて、本体のパッケージもリニューアル発売。
<商品特長>
・ヘッド裏を取り外して洗える清潔設計
・軽々動くこまわりヘッドで、ソファ下、ベッド下など3cmのスキマにも届く!
・角の汚れを逃さない「コーナーフラット形状」で、汚れを逃がさずキャッチ


【参考】ワイパーシート使用後、ワイパー本体のヘッド裏を洗うことで菌の発生を抑制※6
<検証方法>
➀「キレキラ!フロアワイパー」に「キレキラ!フロアワイパーウエットシート」を取り付け、床掃除を実施。(シート片面で掃除後、シートを裏返しもう片面でも掃除)
➁【A】はヘッドを取り外し、軽く水洗いした後に薄めた中性洗剤で洗い、軽く水気を拭き取り。【B】はヘッドを取り外さず、ヘッドのシートが触れた面(ヘッド裏)に残った大きなゴミのみを軽く除去。
➂【A】と【B】のヘッドのシートが触れた面にそれぞれ寒天培地※7を軽く押し当て菌を採取し、25℃で1週間培養。
<検証結果>
「洗わなかったヘッド裏」は菌が顕著に増加
※6:当社基準、当社調べ 2025年7月
※7:【寒天培地】真菌 クリーンスタンプ25CP加サブロー寒天 島津ダイアグノティクス

このプレスリリースには、メディア関係者向けの情報があります
メディアユーザー登録を行うと、企業担当者の連絡先や、イベント・記者会見の情報など様々な特記情報を閲覧できます。※内容はプレスリリースにより異なります。
すべての画像
